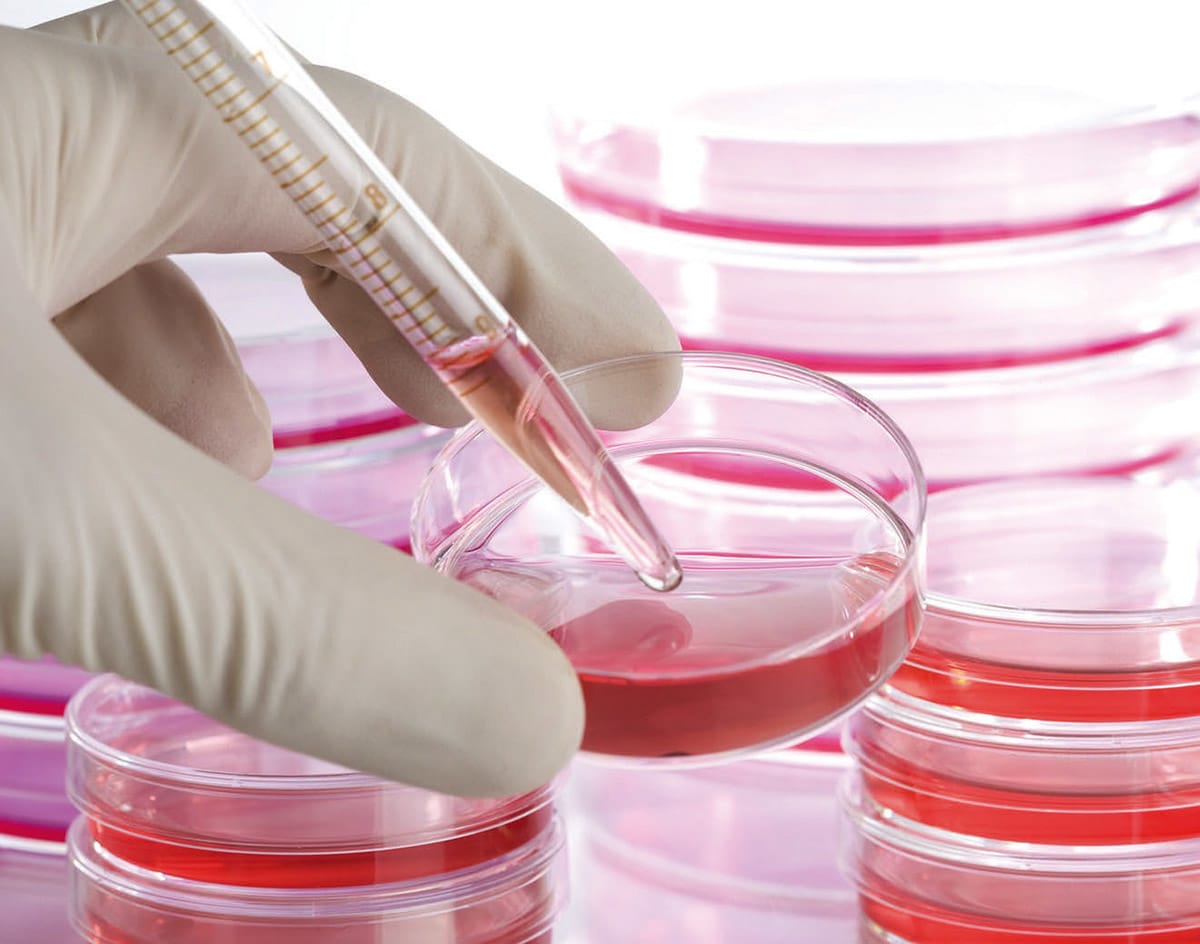

Innovators at NASA Johnson Space Center have designed an apparatus and method that controls the growth and proliferation of 3D biological cells and mammalian tissue in the presence of a pulsating, alternating ionic magnetic resonance field (AIMR). The technology applies a spectrum of electromagnetic fields to control the growth of all mammalian cells and tissues while simultaneously enabling cellular dedifferentiation and lifespan extension through the control of ionic transport and particular ion frequency resonances.
The apparatus comprises a randomized gravity vector multiphasic culture system with a self-feeding growth module, an optionally disposable nutrient module, and a removable AIMR chamber that delivers a pulsating multivariant field to the contents of the culture system. It produces overlapping or fluctuating alternating ionic magnetic resonance frequencies at one or more modal intervals ranging from about 7.8 Hz to about 59.9 Hz to the cell chamber.
The apparatus may yield better regulation that can be manipulated to allow for increased rate of cell growth, faster differentiation, increased cell fidelity, and the induction or suppression of selective physiological genes involved in directing cellular differentiation and dedifferentiation. The use of an AIMR field may provide a significant improvement over existing bioreactors, including pulsating electromagnetic field (PEMF) and time-variance electromagnetic field (TVEMF) cellular growth induced systems, in that AIMR incorporates the modulation of cellular transcription.
The AIMR system utilizes pre-sterilized disposable modules and a removable alternating ionic magnetic resonance chamber, reducing the hazard for contamination, allowing scientists to implement physiological and homeostatic parameters similar to a naturally occurring physiological system.
NASA is actively seeking licensees to commercialize this technology. Please contact NASA’s Licensing Concierge at

